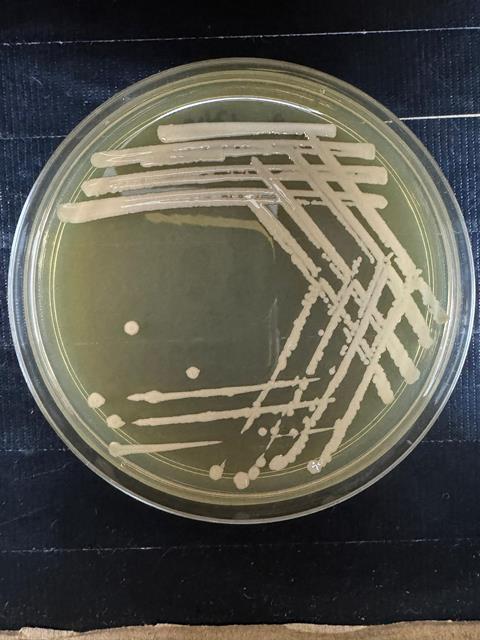
3. Gluconobacter japonicus T12B
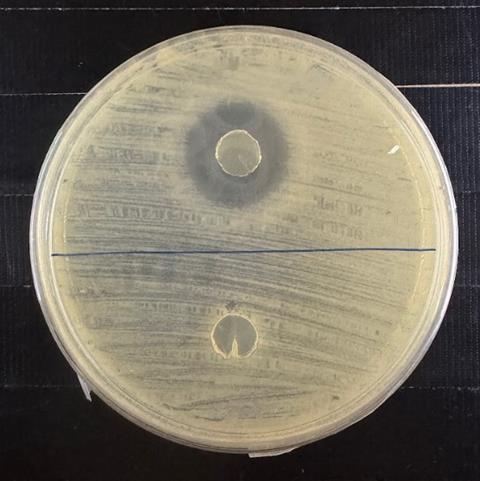
4. Antagonistic activity of strain T12B against Xanthomonas

Scientists have uncovered a bacterium in the microbiome of tomato leaves that can be used to fight back against infection by Xanthomonas, a disease that poses a major challenge to tomato growers worldwide.

The discovery is outlined in ‘Phyllosphere microbiome shifts reveal Gluconobacter japonicus T12B as a biocontrol agent against Xanthomonas in tomato through genomic and functional characterization’, which appears in the Journal of Applied Microbiology, an AMI publication.
The team, at Universiti Malaya, were led to the new biocontrol agent by the discovery that Xanthomonas infection alters the phyllosphere bacterial microbiome of tomato plants, leading to the dominance of the family Acetobacteraceae.
“Guided by this finding, we isolated a naturally occurring bacterium, strain T12B, from the tomato phyllosphere that strongly inhibits Xanthomonas pathogen under both in vitro and in vivo conditions. The strain was identified as Gluconobacter japonicus and our discovery highlights its potential as a natural biocontrol agent for managing bacterial spot disease in tomatoes,” said corresponding author Dr. Chua Kah Ooi.
The research has been conducted by the team at Centre for Research in Biotechnology for Agriculture (CEBAR) and Microbiome Lab in Universiti Malaya, Malaysia since 2022.
Phyllosphere microbiome
“We investigated the tomato phyllosphere microbiome, specifically the bacterial community living on leaf surfaces to understand how it changes when the plants are infected by Xanthomonas,” Dr Chua said. “Our goal was to identify naturally occurring bacteria from the leaf surfaces that are capable of suppressing Xanthomonas. These beneficial bacteria could serve as potential biological control agents against bacterial spot disease in tomatoes, thus offering eco-friendly alternatives to agrochemicals and antibiotics.”

The scientists cultivated tomato plants in a greenhouse and challenged them with a strain of Xanthomonas pathogen. At 21 days post-inoculation, they profiled the phyllosphere bacterial microbiome on both healthy and infected tomato leaves using 16S rRNA gene sequencing and analysis. Differential abundance analysis revealed that members of the family Acetobacteraceae were significantly enriched in infected plants.
Antagonistic activity
“Guided by this finding, they selectively isolated bacteria from the tomato phyllosphere and screened them for antagonistic activity against Xanthomonas pathogen. Among the isolates, only strain T12B displayed strong inhibitory activity and produced a large inhibition zone in dual culture assays. In in vivo fruit infection tests, treatment with strain T12B also significantly reduced disease severity.
“We were surprised to find that the bacterial community in the tomato phyllosphere actively responds to Xanthomonas infection, with certain members becoming more abundant during disease development,” Dr Chua said.
“Even more unexpectedly, Acetobacteraceae, the taxon that increased the highest in differential abundance, consists of members like Gluconobacter japonicus strain T12B that showed strong antagonistic activity against Xanthomonas.
“Species of this genus are known for their role in vinegar fermentation, so their biocontrol activity represents an unanticipated functional role within the tomato phyllosphere. These findings suggest that the native phyllosphere microbiome may contribute to the plant’s natural defense against pathogens.”
Potential biocontrol agent
The findings provide new insight into how bacteria in the tomato phyllosphere may naturally help defend plants against bacterial diseases. The discovery of Gluconobacter japonicus strain T12B as a potential biocontrol agent against bacterial spot disease offers an eco-friendly alternative to conventional agrochemicals and antibiotics, which often lead to resistance and environmental harm.
In the long term, harnessing beneficial microbes like T12B could help combat other tomato or plant diseases, and at the same time support more sustainable tomato production and reduce chemical dependence in agriculture.
“The future work of this study will focus on identifying the specific metabolites responsible for the antagonistic activity of strain T12B. We will also evaluate the safety of the strain for plants and humans, and test its efficacy under greenhouse and field conditions, said Dr Chua.“These efforts will help determine the feasibility of developing strain T12B for practical agricultural use and in the long term, for sustainable tomato disease management.”
Background
The study was led by Dr. Kah-Ooi Chua and Dr. Yvonne Liew Jing Mei from Universiti Malaya, Malaysia. The work was supported by the Centre for Research in Biotechnology for Agriculture (CEBAR) and Microbiome Lab in Universiti Malaya through access to research facilities, including the Plant Biotechnology Facility (PBF).
This research was funded by the Ministry of Higher Education Malaysia under the Fundamental Research Grant Scheme (FRGS), the Malaysia Toray Science Foundation, and Universiti Malaya.
‘Phyllosphere microbiome shifts reveal Gluconobacter japonicus T12B as a biocontrol agent against Xanthomonas in tomato through genomic and functional characterization’, is published in the Journal of Applied Microbiology.
No comments yet